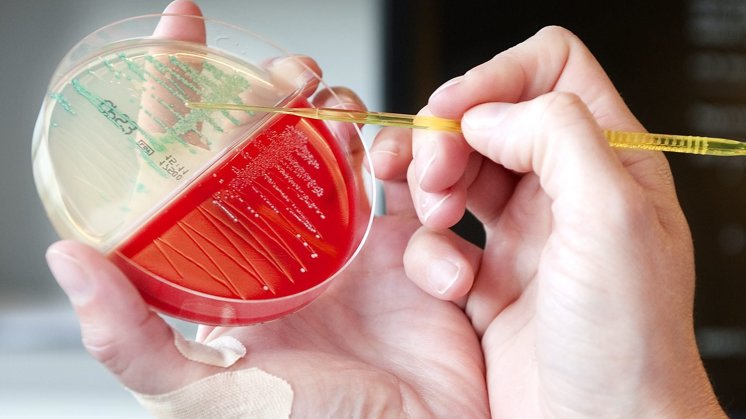
Arkivfoto: Thomas Hansen

Ferie i udlandet: Her skal du passe på resistente bakterier
Flere bakterier udvikler resistens over for antibiotika, og i mange lande skal du derfor være ekstra omhyggelig for at undgå infektioner, der blandt andet kan give lungebetændelse og blodforgiftning
Opdateret kl. 06:20
KØBENHAVN: Sår, der ikke vil hele, lungebetændelse og blodforgiftning. Indtil nu har vi hørt mest om modstandsdygtige bakterier, der er skyld i ovenstående og forårsaget af multiresistente gule stafylokokker.
De kaldes også MRSA, der står for Methicillin Resistente Staphylococcus Aureus. Men stadig flere bakterier bliver immune over for antibiotika, og i de tilfælde er der ikke meget lægerne kan gøre, hvis man får en infektion.
Patienter, der bliver ramt af sådanne bakterier på hospitalet, skal i isolation, så de ikke smitter andre. MRSA kaldes sommetider hospitalsbakterien, men det er ret misvisende. Der er nemlig flere personer, som har erhvervet den i udlandet, eller som er blevet smittet af andre i det omkringliggende samfund, end der er personer, der har pådraget sig bakterien på hospitalet.
Ikke systematisk registreret
Eksempelvis var det, ud af de cirka 2.000 personer, der sidste år blev diagnosticeret med MRSA i Norge, kun en lille minoritet, der blev smittet på hospitalet. Det skriver Forskning.no, ifølge Videnskab.dk.
1.000 personer blev smittet i udlandet, og 800 personer blev smittet af andre i Norge. Men i hvilke lande er der størst risiko for at få infektionen med sig hjem fra ferie?
Folkehelseinstituttet, de norske sundhedsmyndigheder, har ikke systematisk registreret i hvilke lande, de ramte blev smittet - eller hvilket land som udgør den største risiko.
Instituttet har dog MSIS, et helseregister for smitsomme sygdomme, der bidrager til overvågningen af smitsomme sygdomme hos mennesker i Norge. Forekomsten af smitsomme sygdomme bliver løbende og systematisk indsamlet, analyseret, fortolket og rapporteret, og det er én måde at overvåge smitsomme sygdomme blandt befolkningen i Norge.
- De oplysninger, vi modtager i MSIS, afspejler både, hvor nordmændene rejser hen, og de lande, hvor vi allerede ved, at der er en høj forekomst af resistente mikrober, fortæller læge og seniorrådgiver Elisabeth Astrup, afdeling for resistens- og infektionsforebyggelse ved Folkehelseinstituttet til forskning.no, videnskab.dk’s norske søstersite.
Grækenland og Italien
I de seneste år er en række andre bakterier, der forårsager andre infektioner, også blevet resistente i flere og flere lande.
I Europa har især Grækenland og Italien oplevet en masse modstandsdygtige bakterier i de seneste år. Det gælder især resistente E.coli- og klebsiella-bakterier, der kan forårsage lungebetændelse og blodforgiftning.
I Grækenland er forekomsten af resistente klebsiella-bakterier steget fra 2 procent til 30 procent på bare 2 år, fortalte overlæge ved Haukeland Universitetshospital, Per Espen Akselsen, ved et møde om resistens i Norges Kreftforening for nylig.
Få adgang første måned for kun 49 kr.
Prøv Nordjyske nuAllerede abonnent? Log ind
Abonnementet giver adgang til Nordjyske.dk og fornyes automatisk til 109 kr. pr. måned og er uden binding.








